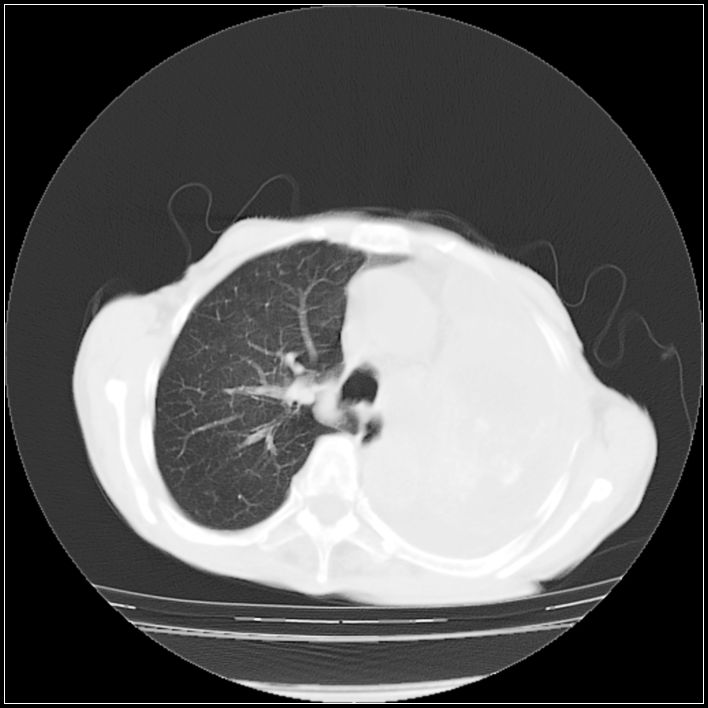

以下是引用ydx_74在2008-5-31 16:08:00的发言:[br]中心性肺癌并左侧肺不张、胸水。
以下是引用影象小辈在2008-5-31 16:25:00的发言:[br]左侧胸腔团状不规则致密影,界欠规整,密度不均匀,其内可见更低密度影及高密度影,并可见包裹性胸腔积液 考虑为1.畸胎瘤 2.肺癌
以下是引用ydx_74在2008-5-31 16:08:00的发言:[br]中心性肺癌并左侧肺不张、胸水。
以下是引用影象小辈在2008-5-31 16:25:00的发言:[br]左侧胸腔团状不规则致密影,界欠规整,密度不均匀,其内可见更低密度影及高密度影,并可见包裹性胸腔积液 考虑为1.畸胎瘤 2.肺癌
| 欢迎光临 医影在线 (http://bbs.radida.com/bbs/) | Powered by Discuz! X3.2 |